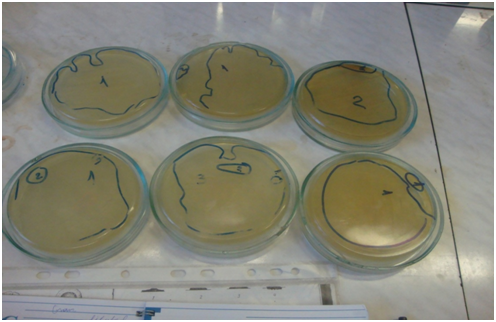

Proceeding Volume 2 Issue 6
Microbiology of foodstuffs
Guillaume Ore
Regret for the inconvenience: we are taking measures to prevent fraudulent form submissions by extractors and page crawlers. Please type the correct Captcha word to see email ID.

Department of Food Biotechnology, Ural Federal University, Russia
Correspondence: Guillaume Ore, Ural Federal University. Institute of Chemical Engineering, Food biotechnology: 19, Mira Street, 620002 Yekaterinburg, Russia
Received: February 15, 2016 | Published: August 30, 2016
Citation: Ore G. Microbiology of foodstuffs. MOJ Food Process Technol. 2016;2(6):201-203. DOI: 10.15406/mojfpt.2016.02.00057
Download PDF
Introduction
- Microorganisms are a large group of mostly single-celled organisms, which can be distinguished only under the microscope, with the characteristic size of less than 0.1 mm and are organized easier than plants and animals.
- Microorganisms, which are capable to cause infections in humans and animals, are called as pathogens (hazardous under any conditions) or opportunistic (dangerous under certain conditions). Opportunistic pathogens such as Escherichia, Proteus, Klebsiella, Enterobacter, Serratiabecome pathogenic only when ingested in large amounts or penetrate into a weakened body.
- Pathogenic organisms cause disease in humans, animals and plants. Other microorganisms cause the loss of agricultural production, leading to depletion of soil nitrogen, result in water pollution, the accumulation of toxic substances (e.g, microbial toxins).
- Microorganisms that are permanent inhabitants of the surfaces and cavities of human or animal body, are called sanitary-indicative microorganisms. They can be found in the environmental objects, contaminated secretions, as well as in human or animal body.
- The favorable range of temperatures for the active microorganisms’ propagation is 20-37 °C, therefore meat, fish, milk and other products in warm room conditions becomes perishable very soon. Various products contain different amounts of pathogenic and opportunistic microorganisms. In order to bring nutrition into a healthy state, it is necessary to choose the right products and to know the conditions of their storage and preparation. Therefore, it is very important to know which foodstuff has a high content of microorganisms both pathogenic and opportunistic.
Purpose
The purpose of this course work is to determine the number of colonies of various types of microorganisms in the test foodstuffs (bread, fish and potato) and to identify which foodstuffs are the most and least contaminated by microorganisms.
Materials and methods
Materials
Table 1
Objects |
Reagents |
Materials |
Equipment |
Bread
Fish
Potato |
Peptone
Agar nutrient media
Crystal Violet
Iodine solution
Ethanol
Safranin
Water |
Tubes
Microbiological loops
Petri dishes |
Sterile container
Pasteur Oven
Incubator |
Methods
Inoculating
- Sterilize Petri dishes during 2h/130 °C and simultaneously prepare the agar nutrient medium by pouring 17.65 g into 500 ml of distilled water. Boil 2 minutes and filtrate before sterilization 120 °C/20 minutes. Fill agar culture medium into 6Petri dishes (number of test samples), give some time to cool down.
- Prepare peptone water (1 g of peptone, 0.5 g salt per 100 ml water). Sterilize 15 minutes under a boiling water bath.
- Prepare the solution of the food product: 1 g of product is dissolved in 50 ml of peptone water (non diluted solution). From this solution prepare another solution (diluted solution) taking 1 ml in 9ml of peptone water.
- Make bacterial inoculation in Petri dishes with microbiological loops flambed in flame.
- Cover plates and flip them. Microorganisms’ colonies are grown in an incubator at 37 °C for 4-6 days.
- Count colonies of microorganisms, determine their types and characteristics.
Gram staining
- Make a smear of cell sample to be stained. Heat to fix the sample to the slide by carefully passing the slide with a drop or small piece of sample on it through a Bunsen burner or flaming flame three times.
- Add the primary stain (crystal violet) to the sample/slide and incubate for 3 minutes.
- Add Gram's iodine for 1 minute- this is a mordant, or an agent that fixes the crystal violet to the bacterial cell wall.
- Rinse sample/slide with alcohol for ~3 seconds and rinse with a gentle stream of water. The alcohol will decolorize the sample if it is Gram negative, removing the crystal violet. However, if the alcohol remains on the sample for too long, it may also decolorize Gram positive cells.
- Add the secondary stain, safranin, to the slide and incubate for 5 minutes. Wash with a gentle stream of water for a maximum of 5 seconds. If the bacteria is Gram positive, it will retain the primary stain (crystal violet) and not take the secondary stain (safranin), causing it to look violet/purple under a microscope. If the bacterium is Gram negative, it will lose the primary stain and take the secondary stain, causing it to appear red when viewed under a microscope.1-6
Results and discussion
- According to our results, potato contains more microorganisms by number of colonies : 3 types of colonies in non diluted and diluted sample.
- About Gram staining, the same samples have the two types of Gram: Bacilli and Cocci Gram positive and negative. This means potato is the most contaminated by microorganisms.
- As for bread, despite its very low water content, it has the same number of colonies as fish that was cooked and rich in water. Which foodstuffs between bread and fish could be the least contaminated by microorganisms? (Tables 2 & 3, Figures 1-3).
Foodstuffs |
Types and
Number of
Colonies |
Characteristics |
Bread |
Non diluted |
2 |
The 2 colonies : round by shape, convex by profile, regular by structure |
diluted |
1 |
Different folded by shape, convex by profile, regular by structure |
Fish |
Non diluted |
2 |
The 2 colonies : round by shape, convex by profile, regular by structure |
diluted |
1 |
Coarse, grained, round by shape, large |
Potato |
Non diluted |
3 |
1: coarse, grained, round by shape, large
2: concentrated by shape, growing into agar by profile, large, grained by structure
3: amoebiform by shape, grained by profile, homogeneous by structure |
diluted |
3 |
1 -3 are round, plan granulous.
2: quite different. It is like mould, irregular by shape, convex by profile, fibrous by structure |
Table 2 Characteristics of the colonies on Food stuffs
Foodstuffs |
Gram staining |
Bread |
Non diluted |
Gram positive : Bacilli and Cocci |
|
diluted |
Gram positive : Bacilli and Cocci |
Fish |
Non diluted |
Gram positive : Bacilli and Cocci |
|
diluted |
Gram positive : Bacilli and Cocci |
Potato |
Non diluted |
Gram negative |
|
diluted |
Gram Positive |
Table 3 Gram staining on the food stuffs

Figure 1 Incubated Food stuffs
Figure 2 Colonies developed on the food stuffs.
Summary
- Peptone water by its composition in salt, is used for supporting growth and after utilizing the nutrients (peptone) minimizes the chances of cell death.
- A solid medium (nutrient agar) is a general purpose medium supporting growth of a wide range of non-fastidious microorganisms for their isolation from foodstuffs, containing peptone, beef extract/yeast extract, sodium chloride, agar, distilled water and neutral pH. Microorganisms’ colonies are grown in an incubator at 37 °C for 4-6 days.
- Gram staining is a common technique used to differentiate two large groups of bacteria based on their different cell wall constituents: Gram positive and Gram negative.
Conclusion
- The purpose of our course work was to determine the number of colonies of various types of microorganisms in the test food stuffs (bread, fish and potato) and to identify which foodstuffs are the most and least contaminated by microorganisms. We have seen different types and characteristics of colonies and Gram staining. In potato, we have seen several types of bacteria than the other foodstuffs. We can say that potato is the most contaminated.
- However, we don’t have the quality criteria in order to decide about microbiological quality.
Acknowledgements
Conflict of interest
The author declares no conflict of interest.
References

©2016 Ore. This is an open access article distributed under the terms of the,
which
permits unrestricted use, distribution, and build upon your work non-commercially.


